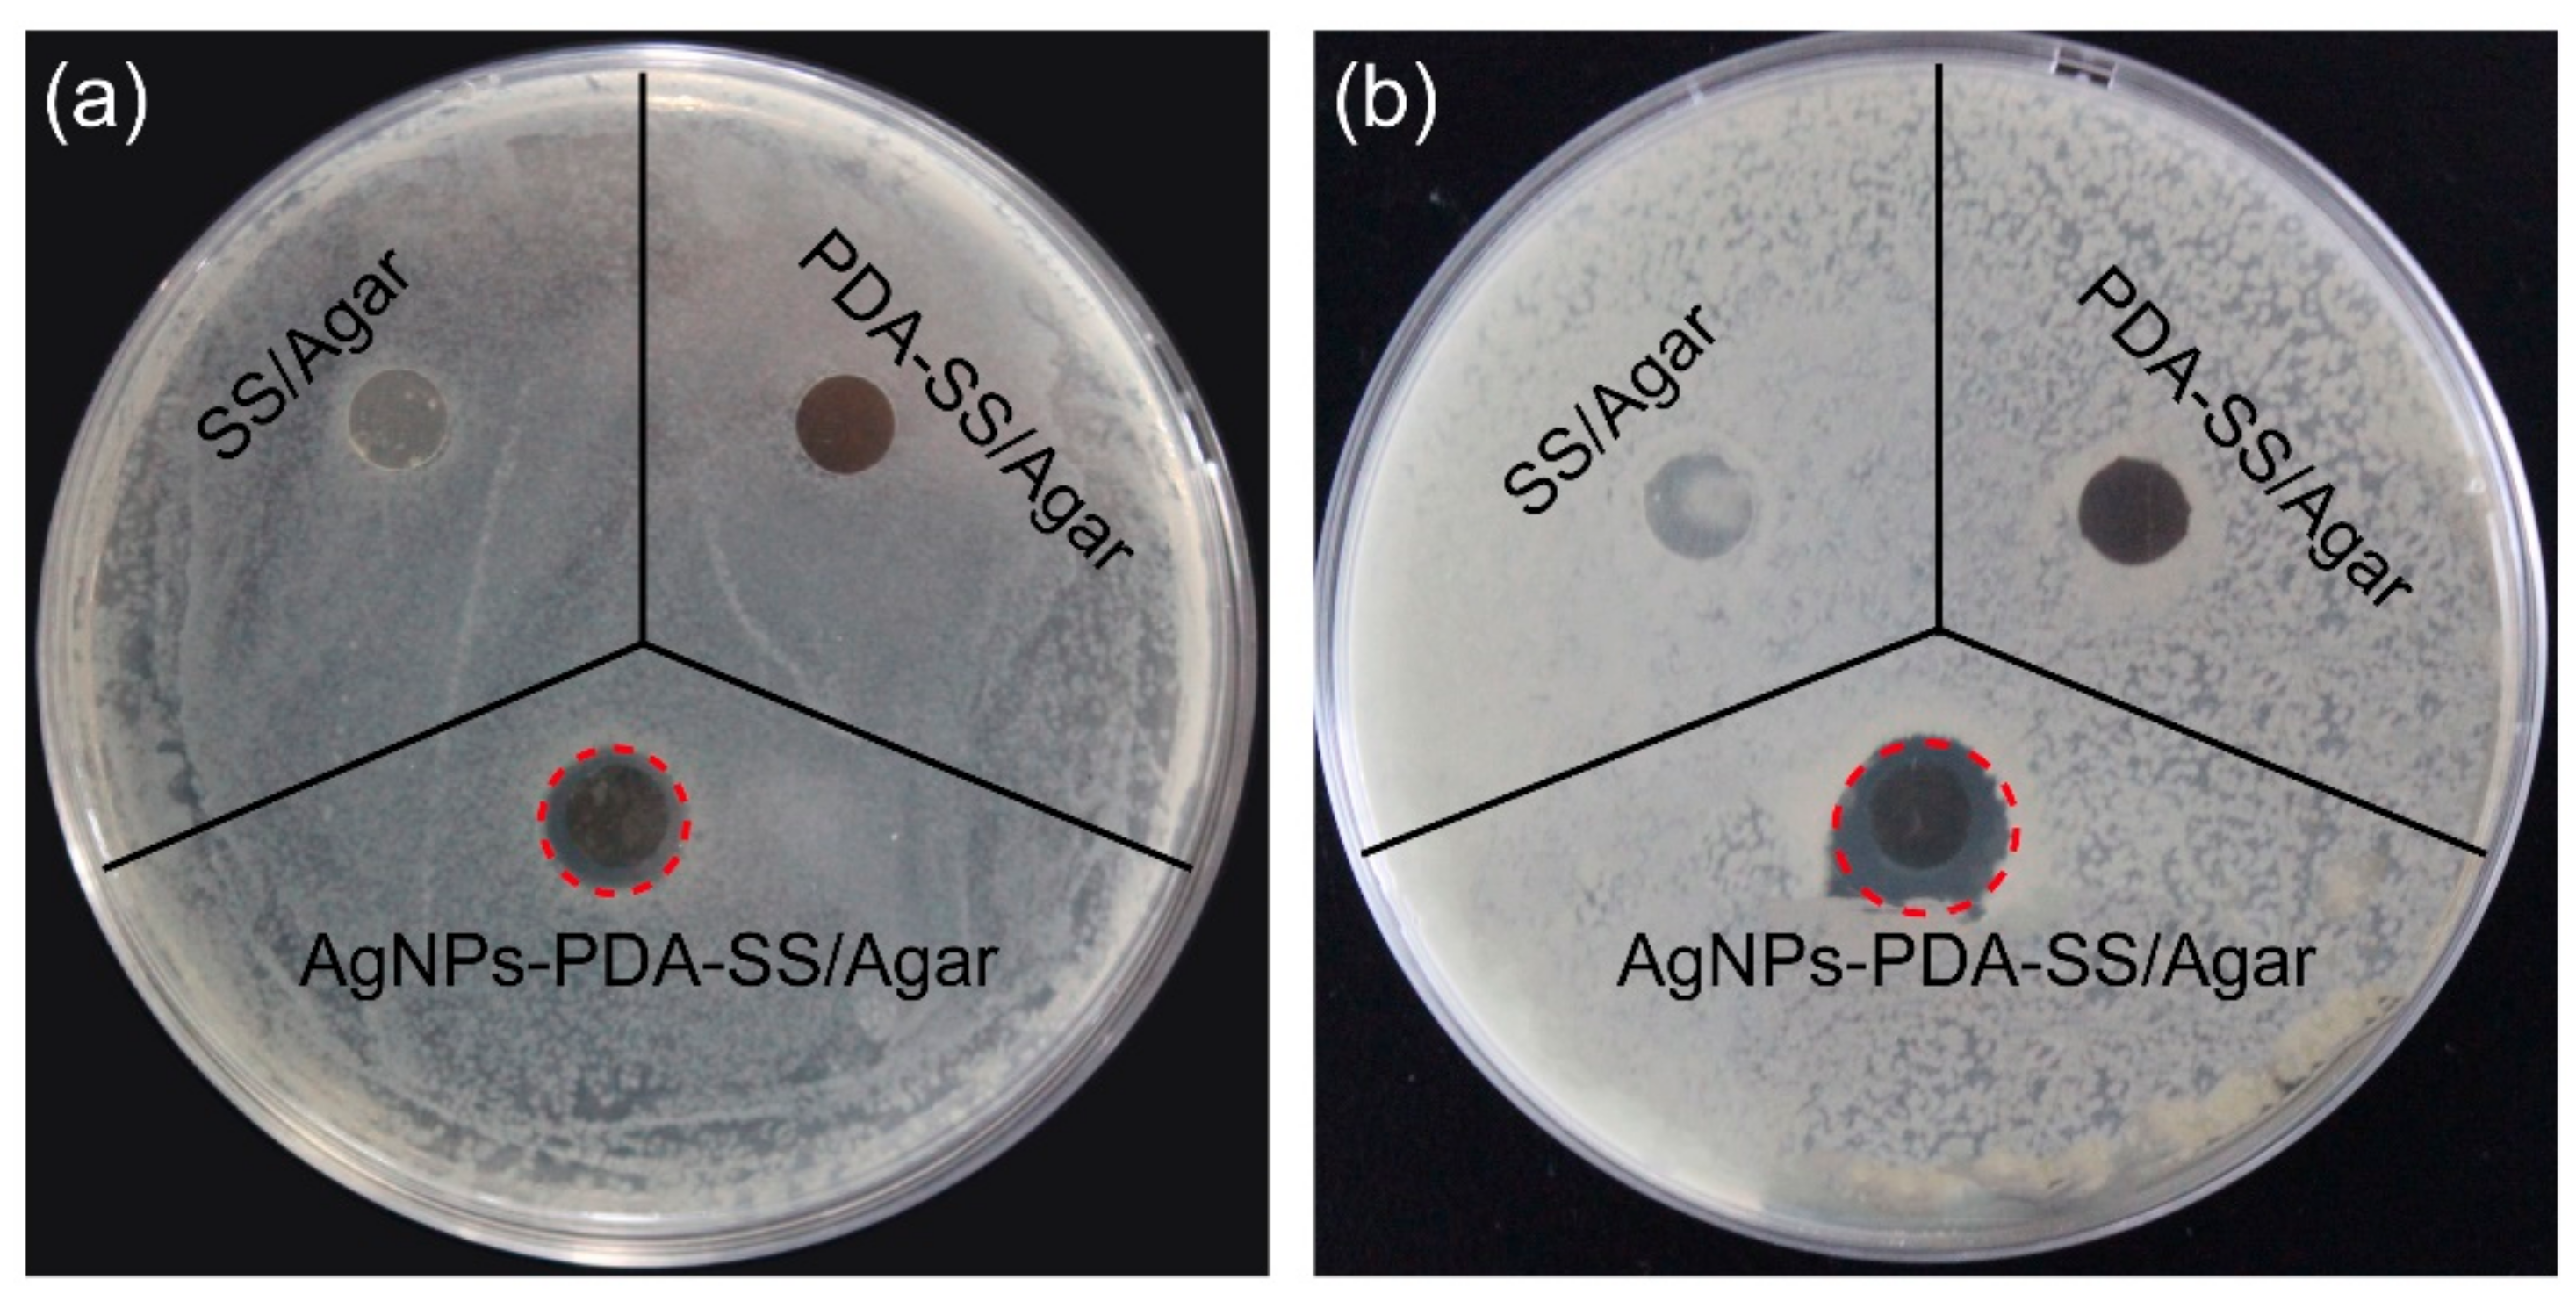

Polydopamine-Assisted Silver Nanoparticle Self-Assembly on Sericin/Agar Film for Potential Wound Dressing Application
Abstract
:1. Introduction
2. Results and Discussion
2.1. Scanning Electron Microscope (SEM), Energy Dispersive Spectroscopy (EDS)
2.2. Fourier Transform Infrared Spectroscopy (FT-IR)
2.3. X-ray Diffraction (XRD)
2.4. Wettability and Water Uptake Ability
2.5. Mechanical Properties
2.6. Inhibition Zone Assay
2.7. Bacterial Growth Curve
2.8. Antimicrobial Stability
2.9. Cytocompatibility
3. Materials and Methods
3.1. Materials and Chemicals
3.2. Preparation of AgNPs-PDA-SS/Agar Film
3.3. Material Characteristics
3.4. Hydrophilicity
3.5. Water Absorption Ratio and Moisture Retention Capacity
3.6. Mechanical Properties
3.7. Inhibition Zone Assay
3.8. Growth Curve Assay
3.9. Antimicrobial Stability
3.10. Cytotoxicity
3.11. Statistics
4. Conclusions
Author Contributions
Funding
Conflicts of Interest
References
- Ouattar, B.; Simard, R.E.; Piett, G.; Bégin, A.; Holley, R.A. Inhibition of surface spoilage bacteria in processed meats by application of antimicrobial films prepared with chitosan. Int. J. Food. Microbiol. 2000, 62, 139–148. [Google Scholar] [CrossRef]
- Sondi, I.; Salopeksondi, B. Silver nanoparticles as antimicrobial agent: A case study on E. Coli as a model for gram-negative bacteria. J. Colloid Interf. Sci. 2004, 275, 177–182. [Google Scholar] [CrossRef] [PubMed]
- Huang, L.; Zhao, S.; Wang, Z.; Wu, J.; Wang, J.; Wang, S. In situ immobilization of silver nanoparticles for improving permeability, antifouling and anti-bacterial properties of ultrafiltration membrane. J. Membr. Sci. 2016, 499, 269–281. [Google Scholar] [CrossRef]
- Zhang, Y.Q. Applications of natural silk protein sericin in biomaterials. Biotechnol. Adv. 2003, 20, 91–100. [Google Scholar] [CrossRef]
- Yang, M.; Wang, Y.; Cai, R.; Tao, G.; Chang, H.; Ding, C.; Zuo, H.; Shen, H.; Zhao, P.; He, H. Preparation and characterization of silk sericin/glycerol films coated with silver nanoparticles for antibacterial application. Sci. Adv. Mater. 2018, 10, 1–8. [Google Scholar] [CrossRef]
- Aramwit, P.; Siritientong, T.; Kanokpanont, S.; Srichana, T. Formulation and characterization of silk sericin-pva scaffold crosslinked with genipin. Int. J. Biol. Macromol. 2010, 47, 668–675. [Google Scholar] [CrossRef] [PubMed]
- Zhaorigetu, S.; Yanaka, N.; Sasaki, M.; Watanabe, H.; Kato, N. Inhibitory effects of silk protein, sericin on uvb-induced acute damage and tumor promotion by reducing oxidative stress in the skin of hairless mouse. J. Photochem. Photobiol. B Biol. 2003, 71, 11–17. [Google Scholar] [CrossRef]
- Kundu, B.; Kundu, S.C. Silk sericin/polyacrylamide in situ forming hydrogels for dermal reconstruction. Biomaterials 2012, 33, 7456–7467. [Google Scholar] [CrossRef] [PubMed]
- Chlapanidas, T.; Faragò, S.; Lucconi, G.; Perteghella, S.; Galuzzi, M.; Mantelli, M.; Avanzini, M.A.; Tosca, M.C.; Marazzi, M.; Vigo, D. Sericins exhibit ROS-scavenging, anti-tyrosinase, anti-elastase, and in vitro immunomodulatory activities. Int. J. Biol. Macromol. 2013, 58, 47–56. [Google Scholar] [CrossRef] [PubMed]
- Chlapanidas, T.; Perteghella, S.; Leoni, F.; Faragò, S.; Marazzi, M.; Rossi, D.; Martino, E.; Gaggeri, R.; Collina, S. TNF-α blocker effect of naringenin-loaded sericin microparticles that are potentially useful in the treatment of psoriasis. Int. J. Mol. Sci. 2014, 15, 13624–13636. [Google Scholar] [CrossRef] [PubMed]
- Faragò, S.; Lucconi, G.; Perteghella, S.; Vigani, B.; Tripodo, G.; Sorrenti, M.; Catenacci, L.; Boschi, A.; Faustini, M.; Vigo, D. A dry powder formulation from silk fibroin microspheres as a topical auto-gelling device. Pharm. Dev. Technol. 2016, 21, 453–462. [Google Scholar] [CrossRef] [PubMed]
- Bari, E.; Arciola, C.R.; Vigani, B.; Crivelli, B.; Moro, P.; Marrubini, G.; Sorrenti, M.; Catenacci, L.; Bruni, G.; Chlapanidas, T. In vitro effectiveness of microspheres based on silk sericin and chlorella vulgaris or arthrospira platensis for wound healing applications. Materials 2017, 10, 983. [Google Scholar] [CrossRef] [PubMed]
- Perteghella, S.; Martella, E.; De Girolamo, L.; Perucca Orfei, C.; Pierini, M.; Fumagalli, V.; Pintacuda, D.V.; Chlapanidas, T.; Viganò, M.; Faragò, S. Fabrication of innovative silk/alginate microcarriers for mesenchymal stem cell delivery and tissue regeneration. Int. J. Mol. Sci. 2017, 18, 1829. [Google Scholar] [CrossRef] [PubMed]
- Crivelli, B.; Perteghella, S.; Bari, E.; Sorrenti, M.; Tripodo, G.; Chlapanidas, T.; Torre, M.L. Silk nanoparticles: From inert supports to bioactive natural carriers for drug delivery. Soft Matter 2018, 14, 546–557. [Google Scholar] [CrossRef] [PubMed]
- Bari, E.; Perteghella, S.; Faragò, S.; Torre, M.L. Association of silk sericin and platelet lysate: Premises for the formulation of wound healing active medications. Int. J. Biol. Macromol. 2018, 119, 37–47. [Google Scholar] [CrossRef] [PubMed]
- Bari, E.; Perteghella, S.; Marrubini, G.; Sorrenti, M.; Catenacci, L.; Tripodo, G.; Mastrogiacomo, M.; Mandracchia, D.; Trapani, A.; Faragò, S. In vitro efficacy of silk sericin microparticles and platelet lysate for intervertebral disk regeneration. Int. J. Biol. Macromol. 2018, 118, 792–799. [Google Scholar] [CrossRef] [PubMed]
- Cai, R.; Tao, G.; He, H.; Song, K.; Zuo, H.; Jiang, W.; Wang, Y. One-step synthesis of silver nanoparticles on polydopamine-coated sericin/polyvinyl alcohol composite films for potential antimicrobial applications. Molecules 2017, 22, 721. [Google Scholar] [CrossRef] [PubMed]
- Reddy, J.P.; Rhim, J.W. Characterization of bionanocomposite films prepared with agar and paper-mulberry pulp nanocellulose. Carbohydr. Polym. 2014, 110, 480–488. [Google Scholar] [CrossRef] [PubMed]
- Wang, Y.; Cai, R.; Tao, G.; Wang, P.; Zuo, H.; Zhao, P.; Umar, A.; He, H. A novel AgNPs/sericin/agar film with enhanced mechanical property and antibacterial capability. Molecules 2018, 23, 1821. [Google Scholar] [CrossRef] [PubMed]
- Liu, L.; Cai, R.; Wang, Y.; Tao, G.; Ai, L.; Wang, P.; Yang, M.; Zuo, H.; Zhao, P.; Shen, H. Preparation and characterization of AgNPs in situ synthesis on polyelectrolyte membrane coated sericin/agar film for antimicrobial applications. Materials 2018, 11, 1205. [Google Scholar] [CrossRef] [PubMed]
- Aramwit, P.; Kanokpanont, S.; Nakpheng, T.; Srichana, T. The effect of sericin from various extraction methods on cell viability and collagen production. Int. J. Mol. Sci. 2010, 11, 2200–2211. [Google Scholar] [CrossRef] [PubMed]
- He, H.; Rui, C.; Wang, Y.; Gang, T.; Guo, P.; Hua, Z.; Chen, L.; Liu, X.; Ping, Z.; Xia, Q. Preparation and characterization of silk sericin/pva blend film with silver nanoparticles for potential antimicrobial application. Int. J. Biol. Macromol. 2017, 104, 457. [Google Scholar] [CrossRef] [PubMed]
- Seo, D.; Kim, J. Effect of the molecular size of analytes on polydiacetylene chromism. Adv. Funct. Mater. 2010, 20, 1397–1403. [Google Scholar] [CrossRef]
- Cui, J.; Wang, Y.; Postma, A.; Hao, J.; Hosta-Rigau, L.; Caruso, F. Monodisperse polymer capsules: Tailoring size, shell thickness, and hydrophobic cargo loading via emulsion templating. Adv. Funct. Mater. 2010, 20, 1625–1631. [Google Scholar] [CrossRef]
- Zhu, L.P.; Yu, J.Z.; Xu, Y.Y.; Xi, Z.Y.; Zhu, B.K. Surface modification of pvdf porous membranes via poly(dopa) coating and heparin immobilization. Colloid Surface B 2009, 69, 152–155. [Google Scholar] [CrossRef] [PubMed]
- Peng, F.; Wang, Q.; Shi, R.; Wang, Z.; You, X.; Liu, Y.; Wang, F.; Gao, J.; Mao, C. Fabrication of sesame sticks-like silver nanoparticles/polystyrene hybridnanotubes and their catalytic effects. Sci. Rep. 2016, 6, 39502. [Google Scholar] [CrossRef] [PubMed]
- Xu, H.; Zhang, G.; Xu, K.; Wang, L.; Yu, L.; Xing, M.; Qiu, X. Mussel-inspired dual-functional peg hydrogel inducing mineralization and inhibiting infection in maxillary bone reconstruction. Mat. Sci. Eng. A-Struct. 2018, 90, 379–386. [Google Scholar] [CrossRef] [PubMed]
- Ke, W.; Yun, Y.; Zhang, Y.; Deng, J.; Lin, C. Antimicrobial activity and cytocompatibility of silver nanoparticles coated catheters via a biomimetic surface functionalization strategy. Int. J. Nanomed. 2015, 10, 7241–7252. [Google Scholar]
- Tacora Cauna, R.L.; Luna Mercado, G.I.; Bravo Portocarrero, R.; Mayta Hancco, J.; Choque Yucra, M.; Ibañez Quispe, V. Effect ofthe expansion pressure process by explosion and toast temperature on some functional and physicochemical characteristics on two varieties of cañihua (chenopodium pallidicaule aellen). Journal De Ciencia Y Tecnologia Agraria 2010, 10, 188–198. [Google Scholar]
- Lu, Q.; Hu, X.; Wang, X.; Kluge, J.A.; Lu, S.; Cebe, P.; Kaplan, D.L. Water-insoluble silk films with silk i structure. Acta Biomater. 2010, 6, 1380–1387. [Google Scholar] [CrossRef] [PubMed]
- Dreyer, D.R.; Miller, D.J.; Freeman, B.D.; Paul, D.R.; Bielawski, C.W. Elucidating the structure of poly(dopamine). Langmuir 2012, 28, 6428. [Google Scholar] [CrossRef] [PubMed]
- Jin, Y.; Deng, D.; Cheng, Y.; Kong, L.; Xiao, F. Annealing-free and strongly adhesive silver nanowire networks with long-term reliability by introduction of a nonconductive and biocompatible polymer binder. Nanoscale 2014, 6, 4812–4818. [Google Scholar] [CrossRef] [PubMed]
- Gómezordóñez, E.; Rupérez, P. Ftir-atr spectroscopy as a tool for polysaccharide identification in edible brown and red seaweeds. Food Hydrocolloid 2011, 25, 1514–1520. [Google Scholar] [CrossRef]
- Tao, W.; Li, M.; Xie, R. Preparation and structure of porous silk sericin materials. Macromol. Mater. Eng. 2010, 290, 188–194. [Google Scholar] [CrossRef]
- Jiang, Y.; Lu, Y.; Zhang, L.; Liu, L.; Dai, Y.; Wang, W. Preparation and characterization of silver nanoparticles immobilized on multi-walled carbon nanotubes by poly(dopamine) functionalization. J. Nanopart. Res. 2012, 14, 1–10. [Google Scholar] [CrossRef]
- Roy, K.; Sarkar, C.K.; Ghosh, C.K. Rapid colorimetric detection of hg2+ ion by green silver nanoparticles synthesized using dahlia pinnata leaf extract. Green. Process. Synth. 2015, 4, 455–461. [Google Scholar] [CrossRef]
- Kanmani, P.; Rhim, J.W. Antimicrobial and physical-mechanical properties of agar-based films incorporated with grapefruit seed extract. Carbohydr. Polym. 2014, 102, 708–716. [Google Scholar] [CrossRef] [PubMed]
- Kumar, P.T.; Lakshmanan, V.K.; Anilkumar, T.V.; Ramya, C.; Reshmi, P.; Unnikrishnan, A.G.; Nair, S.V.; Jayakumar, R. Flexible and microporous chitosan hydrogel/nano zno composite bandages for wound dressing: In vitro and in vivo evaluation. ACS Appl Mater Interfaces 2012, 4, 2618–2629. [Google Scholar] [CrossRef] [PubMed]
- Yang, M.; Wang, Y.; Gang, T.; Rui, C.; Peng, W.; Liu, L.; Ai, L.; Hua, Z.; Ping, Z.; Umar, A. Fabrication of sericin/agrose gel loaded lysozyme and its potential in wound dressing application. Nanomaterials 2018, 8, 235. [Google Scholar] [CrossRef] [PubMed]
- Yao, Y.; Liu, H.; Ding, X.; Jing, X.; Gong, X.; Zhou, G.; Fan, Y. Preparation and characterization of silk fibroin/poly(l-lactide-co-caprolactone) nanofibrous membranes for tissue engineering applications. J. Bioact. Compat. Pol. 2015, 30, 14825–14829. [Google Scholar] [CrossRef]
- Cai, R.; Tao, G.; He, H.; Guo, P.; Yang, M.; Ding, C.; Zuo, H.; Wang, L.; Zhao, P.; Wang, Y. In situ synthesis of silver nanoparticles on the polyelectrolyte-coated sericin/pva film for enhanced antibacterial application. Materials 2017, 10, 967. [Google Scholar] [CrossRef] [PubMed]
- Wu, J.H.; Wang, Z.; Xu, S.Y. Preparation and characterization of sericin powder extracted from silk industry wastewater. Food Chem. 2007, 103, 1255–1262. [Google Scholar] [CrossRef]
- He, H.; Tao, G.; Wang, Y.; Cai, R.; Guo, P.; Chen, L.; Zuo, H.; Zhao, P.; Xia, Q. In situ green synthesis and characterization of sericin-silver nanoparticle composite with effective antibacterial activity and good biocompatibility. Mat. Sci. Eng. C-Mater. 2017, 80, 509. [Google Scholar] [CrossRef] [PubMed]
- Karim, Z.; Mathew, A.P.; Grahn, M.; Mouzon, J.; Oksman, K. Nanoporous membranes with cellulose nanocrystals as functional entity in chitosan: Removal of dyes from water. Carbohydr. Polym. 2014, 112, 668–676. [Google Scholar] [CrossRef] [PubMed]
- Tao, G.; Cai, R.; Wang, Y.; Song, K.; Guo, P.; Zhao, P.; Zuo, H.; He, H. Biosynthesis and characterization of AgNPs –silk/pva film for potential packaging application. Materials 2017, 10, 667. [Google Scholar] [CrossRef] [PubMed]
- Janisha, J.; Rosamma, A. Deproteinised natural rubber latex grafted poly(dimethylaminoethyl methacrylate)–poly(vinyl alcohol) blend membranes: Synthesis, properties and application. Int. J. Biol. Macromol. 2017, 107, 1821. [Google Scholar]
- Schillinger, U.; Lücke, F.K. Antibacterial activity of lactobacillus sake isolated from meat. Appl. Environ. Microb. 1989, 55, 1901. [Google Scholar]
- Hwang, J.J.; Ma, T.W. Preparation, morphology, and antibacterial properties of polyacrylonitrile/montmorillonite/silver nanocomposites. Mater. Chem. Phys. 2012, 136, 613–623. [Google Scholar] [CrossRef]

| Bacteria | SS/Agar (cm) | PDA-SS/Agar (cm) | AgNPs-PDA-SS/Agar (cm) |
|---|---|---|---|
| E. coli | 1.10 ± 0.00 | 1.10 ± 0.00 | 1.63 ± 0.03 |
| S. aureus | 1.10 ± 0.00 | 1.10 ± 0.00 | 1.91 ± 0.11 |
© 2018 by the authors. Licensee MDPI, Basel, Switzerland. This article is an open access article distributed under the terms and conditions of the Creative Commons Attribution (CC BY) license (http://creativecommons.org/licenses/by/4.0/).
Share and Cite
Liu, L.; Cai, R.; Wang, Y.; Tao, G.; Ai, L.; Wang, P.; Yang, M.; Zuo, H.; Zhao, P.; He, H. Polydopamine-Assisted Silver Nanoparticle Self-Assembly on Sericin/Agar Film for Potential Wound Dressing Application. Int. J. Mol. Sci. 2018, 19, 2875. https://doi.org/10.3390/ijms19102875
Liu L, Cai R, Wang Y, Tao G, Ai L, Wang P, Yang M, Zuo H, Zhao P, He H. Polydopamine-Assisted Silver Nanoparticle Self-Assembly on Sericin/Agar Film for Potential Wound Dressing Application. International Journal of Molecular Sciences. 2018; 19(10):2875. https://doi.org/10.3390/ijms19102875
Chicago/Turabian StyleLiu, Liying, Rui Cai, Yejing Wang, Gang Tao, Lisha Ai, Peng Wang, Meirong Yang, Hua Zuo, Ping Zhao, and Huawei He. 2018. "Polydopamine-Assisted Silver Nanoparticle Self-Assembly on Sericin/Agar Film for Potential Wound Dressing Application" International Journal of Molecular Sciences 19, no. 10: 2875. https://doi.org/10.3390/ijms19102875
APA StyleLiu, L., Cai, R., Wang, Y., Tao, G., Ai, L., Wang, P., Yang, M., Zuo, H., Zhao, P., & He, H. (2018). Polydopamine-Assisted Silver Nanoparticle Self-Assembly on Sericin/Agar Film for Potential Wound Dressing Application. International Journal of Molecular Sciences, 19(10), 2875. https://doi.org/10.3390/ijms19102875

